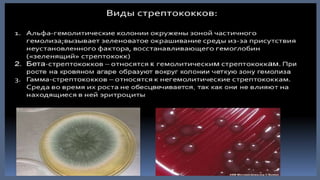
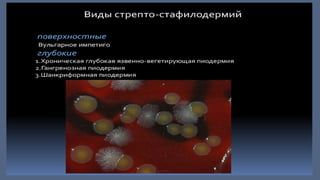

Документ детализирует виды пиодермии, такие как стафилодермия и стрептодермия, с их классификацией и специфическими клиническими проявлениями. Описаны как поверхностные, так и глубокие формы заболеваний, их симптомы, течения и последствия. Также представлены рекомендации по диагностике и лечению различных форм пиодермии с использованием антибактериальных препаратов.

![• Цефотаксим внутривенно или внутримышечно: детям с массой тела менее 50 кг – 50-100 мг на кг массы тела в сутки с
интервалом введения 6–8 часов, детям с массой тела более 50 кг и взрослым – 2,0-6,0 г в сутки с интервалом введения 8-
12 часов. Курс лечения 5-10 дней [4, 8, 9].
• Цефтриаксон внутримышечно: детям в возрасте до 12 лет – 50-75 мг на кг массы тела 1 раз в сутки, детям в возрасте
старше 12 лет и взрослым – 1,0-2,0 г 1 раз в сутки. Курс лечения 7-10 дней [8, 9].
• Эритромицин перорально: детям в возрасте до 3 месяцев – 20-40 мг на кг массы тела в сутки, детям в возрасте от 3
месяцев до 18 лет – 30-50 мг на кг массы тела в сутки, взрослым – 1,0-4,0 г в сутки в 4 приема. Курс лечения – 5-14 дней.
• Азитромицин перорально: детям – 10 мг на кг массы тела 1 раз в сутки в течение 3 дней, взрослым – 500 мг 1 раз в сутки
течение 3 дней.
• Кларитромицин перорально: детям – 7,5 мг на кг массы тела в сутки, взрослым – 500-1000 мг в сутки. Кратность приема 2
раза в сутки. Курс лечения – 7-10 дней [4].
• Доксициклин перорально: детям в возрасте старше 12 лет и взрослым – 100 мг 2 раза в сутки в течение 10-14 дней [6,
10].
• Ципрофлоксацин 250-500 мг 2 раза в сутки перорально в течение 5-15 дней.
• Левофлоксацин 250-500 мг перорально 1-2 раза в сутки в течение 7-14 дней .
• Офлоксацин 200-400 мг перорально 2 раза в сутки в течение 7-10 дней.
• Клиндамицин перорально: детям – 3-6 мг на кг массы тела 4 раза в сутки, взрослым 150-450 мг 4 раза в сутки. При
парентеральном введении детям 15-40 мг на кг массы тела в сутки, взрослым – 600 мг-2,7 г в сутки, кратность введения
3-4 раза в сутки. Курс лечения – 10 дней [4, 6, 10, 12].
• Сульфаметоксазол + триметоприм перорально: детям в возрасте от 3 до 5 лет – 240 мг 2 раза в сутки; детям в возрасте от
6 до 12 лет – 480 мг 2 раза в сутки; взрослым и детям в возрасте старше 12 лет – 960 мг 2 раза в сутки. Курс лечения – 5-
14 дней.](https://image.slidesharecdn.com/random-250202203326-b546d8cf/85/slide-22-320.jpg)
![Рекомендовано с целью частичного или полного регресса высыпаний при хронической язвенно-вегетирующей и гангренозной
пиодермиях назначение одного из следующих глюкокортикостероидных препаратов для системного применения:
• преднизолон 25-30 мг в сутки внутримышечно в течение 5-7 дней с постепенным снижением дозы вплоть до отмены
• или
• дексаметазон 4 мг (1 мл) 4-6 мг в сутки внутримышечно в течение 5-7 дней с постепенным снижением дозы вплоть до отмены
• или
• бетаметазон 1-2 мл внутримышечно однократно, при необходимости повторить введение через 10 дней [1].
Рекомендовано с целью частичного или полного регресса высыпаний при абсцедирующем фолликулите и перифолликулите головы
назначение изотретиноина 0,5-1,0 мг на кг массы тела в сутки перорально в течение 3-4 месяцев [1].
Рекомендовано с целью частичного или полного регресса высыпаний при рецидивирующих, упорно протекающих формах
пиодермий назначение вакцин, анатоксинов или иммуноглобулинов:
• анатоксин стафилококковый очищенный жидкий в 1 мл 12±2 ЕС стафилококкового анатоксина: в нарастающих дозах: 0,1, 0,3, 0,5,
0,7, 0,9, 1,2 и 1,5 мл подкожно с интервалом 2 суток; на курс лечения – 7 инъекций [1].
• Комментарии: Препарат не применяют одновременно с лечением сывороточными антистафилококковыми препаратами
(иммуноглобулином и плазмой)
• или
• вакцина для лечения стафилококковых инфекций: детям в возрасте от 6 месяцев до 7 лет – 0,1 мл подкожно ежедневно; детям в
возрасте старше 7 лет начальная доза – 0,2 мл подкожно, затем ежедневно увеличивать дозу на 0,1 мл в течение 8 дней.
Повторный курс лечения через 10-15 суток в случае обширных поражениях кожи с рецидивами [1].
• или
• иммуноглобулин человека антистафилококковый жидкий: при легких формах пиодермий 100 МЕ в сутки внутримышечно, при
генерализованной инфекции – 5 МЕ на кг массы тела в сутки внутримышечно, курс лечения – 3-5 инъекций ежедневно или через
день [1].](https://image.slidesharecdn.com/random-250202203326-b546d8cf/85/slide-23-320.jpg)
![Рекомендовано с целью частичного или полного регресса высыпаний для лечения пиодермий стафилококковой этиологии,
сопровождающихся бактериемией и сепсисом, назначение иммуноглобулина:
• иммуноглобулин человека антистафилококковый (в 1 мл не менее 20 МЕ) внутривенно капельно: детям 5-7 МЕ на кг
массы тела, не более 25 МЕ (однократная доза) со скоростью 8–10 капель в 1 мин; взрослым: 5-7 МЕ на кг массы тела
(однократная доза) со скоростью не более 40 капель в 1 мин. На курс 10 инфузий с интервалом 24–72 часа [1].
• Комментарии: Препарат совместим с другими лекарственными средствами.
• или
• иммуноглобулин человека нормальный внутривенно капельно: детям: 3-4 мл на кг массы тела, не более 25 МЕ
(однократная доза) со скоростью 8-10 капель в 1 мин; взрослым: 25-50 мл со скоростью не более 40 капель в 1 мин
через 1-3 суток Курс лечения – 3-10 инфузий.
• Комментарии: Препарат совместим с другими лекарственными средствами.
Рекомендовано при глубоких формах пиодермии для разрешения клинических проявлений УВЧ–терапия. Курс лечения –
5-10 процедур.
2. Хирургическое лечение
• Рекомендовно при пиодермиях, сопровождающихся язвенными дефектами кожи, удаление и выскабливание отдельных
очагов поражения, рассечение и коагуляция свищевых ходов [13].
• Комментарии: Решение о проведении хирургического лечения принимается врачом-хирургом.
3. Иное лечение
• Физиолечения (ИК лазер, фототерапия, УФО терапия)
• Диетотерапия не применяется.
• Обезболивание не применяется.](https://image.slidesharecdn.com/random-250202203326-b546d8cf/85/slide-24-320.jpg)